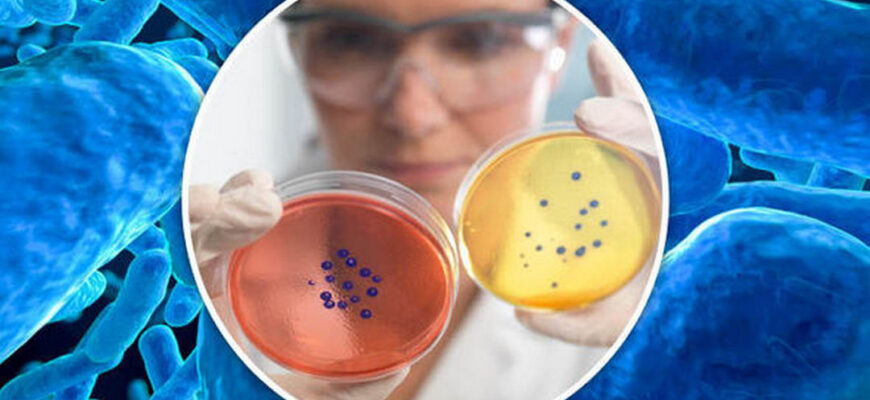
stafilococul auriu lat. staphylococcus aureus

Stafilococul auriu (lat. staphylococcus aureus) este un tip de bacterie care se găsește pe piele, în nas, la axilă (subraț), în zona inghinală, dar și în alte părți ale corpului. Stafilococul auriu este una dintre cele mai frecvente infecții bacteriene la om și reprezintă, totodată, una dintre bacteriile care produce mai multe afecțiuni în organismul uman.
Staphylococcus aureus este cel mai periculos dintre toate speciile de stafilococi. Aceste bacterii gram-pozitive, de culoare mov-violet în câmpul microscopic, au formă de coci și sunt aranjate în grupuri asemănătoare unui ciorchine de strugure.
Stafilococul auriu se regăsește adesea, la nivelul pielii sau al mucoasei nazale la persoanele sănătoase și nu cauzează probleme serioase. Se estimează că până la jumătate dintre adulți au stafilococ auriu, iar aproximativ 15% din populație poartă Staphylococcus aureus în nări. Riscul de a te îmbolnăvi crește în funcție de activitățile sau locurile care implică aglomerație și contact piele pe piele.
Dacă bacteria pătrunde în sistemul circulator, în sistemul osos ori dacă ajunge la plămâni, inimă sau la nivelul articulațiilor, infecțiile cauzate de stafilococul auriu pot avea urmări grave. Stafilococul auriu supraviețuiește la temperaturi extreme, face față acidului gastric și chiar și mediului salin. Aceste organisme pot crește aerob sau anaerob (facultativ) și la temperaturi cuprinse între 18 °C și 40° C.
- Cauzele infecției cu stafilococ auriu
- Cum se transmite stafilococul auriu
- Predispoziția la infecția cu stafilococ auriu
- Simptome stafilococ auriu
- Alte infecții cauzate de stafilococul auriu
- Complicații ale infecției cu stafilococ auriu
- Evaluarea pacientului infectat cu stafilococ auriu
- Tratament pentru stafilococul auriu
- Prevenirea infectării cu stafilococ auriu
Cauzele infecției cu stafilococ auriu
Multe persoane poartă bacteria stafilococului auriu, însă nu dezvoltă niciodată o infecție. Infecțiile cu stafilococ auriu sunt cauzate de mai multe tipuri diferite de germeni stafilococici, inclusiv:
• Staphylococcus aureus rezistent la Meticilină;
• Staphylococcus aureus susceptibil la Meticilină;
• Staphylococcus aureus intermediar sensibil la Vancomicină;
• Staphylococcus aureus rezistent la Vancomicină.
Cum se transmite stafilococul auriu
Stafilococul auriu este contagios și se transmite cu ușurință, prin atingerea persoanei care poartă bacteria. De regulă, pielea funcționează precum o barieră protectoare împotriva infecției, însă dacă există leziuni la nivelul pielii, stafilococul auriu poate pătrunde cu ușurință în țesuturi sau sânge și poate cauza infecții. Folosirea la comun a prosoapelor sau a lenjeriilor de pat cu o persoană infectată favorizează infecția cu stafilococul auriu.
Predispoziția la infecția cu stafilococ auriu
Oricine poate dezvolta o infecție cu stafilococ auriu, deși anumite categorii de persoane prezintă un risc mai mare, inclusiv pacienții cu afecțiuni cronice, cum ar fi diabetul, cancerul, bolile vasculare, eczemele, bolile pulmonare, pacienții cu sistemul imunitar slăbit, care au fost supuși unor proceduri medicale ori persoanele care-și injectează droguri. Potrivit statisticilor, persoanele care își injectează droguri au de 16 ori mai multe riscuri de a dezvolta o infecție gravă cu stafilococ.
De asemenea, riscul unei infecții stafilococice este mai mare pentru pacienții din unitățile de terapie intensivă, pentru cei care au fost supuși anumitor tipuri de intervenții chirurgicale și pentru pacienții care au dispozitive medicale inserate în corp cum ar fi catetere.
Simptome stafilococ auriu
Infecțiile cu stafilococ auriu apar, de obicei, pe piele sub forma unor pungi de puroi înconjurate de piele roșie, dureroasă sau inflamația țesutului conjunctiv subcutanat. Stafilococul auriu se manifestă diferit în funcție de afecțiunea pe care o declanșează. Dar se poate întâmpla ca unele infecții ale pielii cu stafilococ auriu să capete un aspect destul de tipic și să fie confundate cu o mușcătură de păianjen.
Umflăturile provocate de infecțiile cutanate cu stafilococ auriu se pot transforma rapid în abcese pline de puroi. Acestea sunt răni profunde, infectate, bacteriile rămânând în piele. Riscul major este că aceste infecții se pot răspândi adânc în organism, provocând infecții care pot pune viața în pericol, cum ar fi pneumonia.
Cele mai multe infecții cauzate de stafilococul auriu apar la nivelul cutanat sau al țesutului moale cum ar fi:
• abcesul cutanat, ce se manifestă prin apariția unei pungi de puroi la nivel cutanat, care se formează fie într-un folicul de păr, fie într-o glandă seboreică. Abcesul cutanat are ca simptome: inflamarea pielii, apariția pungii de puroi în mijlocul inflamației, durere.
• impedigo – o iritație dureroasă și contagioasă la nivelul pielii, ce se manifestă prin apariția unor bășici pline cu fluid, a căror culoare este similară mierii.
• sindromul stafilococic al pielii opărite (Pemfigus neonatal) – prezent, în special, la bebeluși și copii. Febra, iritațiile și bășicile apărute la nivelul pielii, care capătă aspectul unei arsuri, sunt simptomele cele mai comune ale acestui sindrom.
Alte infecții cauzate de stafilococul auriu
• intoxicația alimentară – simptomele de greață, vărsături, diaree, deshidratare, tensiune arterială scăzută, apar rapid, la câteva ore de la consumul alimentelor contaminate, însă dispar în cel mult o jumătate de zi;
• septicemia – bacteria poate cauza infecții la nivelul organelor interne, oaselor, mușchilor sau dispozitivelor implantate pe cale chirurgicală; febra și tensiunea arterială scăzută sunt simptome specifice septicemiei;
• sindromul de șoc toxic – o afecțiune cu potențial fatal, ce poate fi cauzată de toxinele produse de bacteria stafilococului auriu; apare, în general, în urma unor intervenții chirurgicale și se manifestă prin: greață, vărsături, iritații la nivelul palmelor, confuzie, dureri musculare, diaree și dureri abdominale;
• artrita septică – infecția cu stafilococul auriu poate cauza și artrită septică, afecțiune care afectează, în general, genunchii, umerii, șoldurile sau degetele de la mâini și picioare. Simptomele acestei afecțiuni sunt: inflamarea articulațiilor, durerile articulare severe și febra.
• endocardită – este afecțiunea care se dezvoltă în momentul în care bacteriile afectează zone din inimă, de obicei valvele inimii. Dacă nu este tratată rapid, infecția poate deteriora sau distruge valvele cardiace.
• osteomielita – această afecțiune neobișnuită, dar gravă, apare atunci când un os din corpul este infectat.
• piomiozita – este o infecție bacteriană rară a mușchilor scheletici, care sunt mușchii pe care îi utilizăm ca să ne mișcăm.
• pneumonia – este o infecție comună care provoacă inflamație și acumulare de lichid în sacii de aer ai plămânilor, îngreunând respirația.
Complicații ale infecției cu stafilococ auriu
Deși de cele mai multe ori stafilococul auriu nu cauzează niciun rău, uneori, această bacterie provoacă infecții ce pot fi grave sau letale, cum ar fi:
• sepsisul, când bacteriile se răspândesc în sânge;
• pneumonia, care afectează cel mai adesea pacienții cu boli pulmonare subiacente, inclusiv cei cu ventilatoare mecanice;
• endocardita (infecția valvei cardiace), care poate duce la insuficiență cardiacă sau accident vascular cerebral;
• osteomielita (infecția osoasă), care poate fi cauzată de bacteriile stafilococice, care se deplasează în sânge sau pot fi acolo prin contact direct, cum ar fi după un traumatism ca puncția plăgii piciorului sau abuzul de droguri intravenoase.
Evaluarea pacientului infectat cu stafilococ auriu
Evaluarea unei infecții cu stafilococ auriu presupune analizarea semnelor și simptomelor clinice, precum și a istoricului și a constatărilor fizice. În majoritatea cazurilor, culturile de rutină vor pune diagnosticul cum ar fi hemoculturi sau culturi din spută.
De asemenea, este recomandat ca în cazul în care se prelevează probe de la pacienți pentru identificarea agenților patogeni în laboratorul de microbiologie, acest lucru să se facă cu atenție, deoarece prezența stafilococului auriu în piele sau mucoasă nu indică neapărat o infecție, deoarece aceste organisme sunt frecvent prezente. În plus, testarea susceptibilității la consumul de droguri este adesea necesară pentru a ghida tratamentul.
Tratament pentru stafilococul auriu
Tratamentul depinde de tipul de infecție cauzată de bacterii. În urma unui examen fizic și a analizei de laborator a unei mostre de țesut recoltat de la pacient, medicul va stabili diagnosticul.
Odată cu stabilirea diagnosticului, medicul îți va recomanda un tratament pe bază de antibiotice și drenaj.
În general, penicilina rămâne medicamentul de elecție în infecția cu stafilococul auriu. Este important să nu întrerupi tratamentul recomandat de medic, chiar dacă începi să te simți bine, cu excepția cazului în care medicul te sfătuiește să faci altfel. Discută cu medicul dacă nu observi îmbunătățiri după câteva zile de tratament sau dacă infecția se agravează.
Pentru cazurile ușoare de infecție cu stafilococ auriu, medicul poate drena furuncul și va acoperi rana cu un pansament curat sau un bandaj. Acesta va trebui schimbat în mod regulat. De altfel, specialistul îți va prescrie și un unguent pe care să îl aplici pe zona respectivă.
Bacteriile stafilococice sunt foarte adaptabile și multe soiuri au devenit rezistente la unul sau mai multe antibiotice. Astfel, tratamentul poate fi schimbat, pentru că stafilococul auriu poate dezvolta rapid rezistență la anumite antibiotice. Creșterea tulpinilor rezistente la antibiotice ale bacteriilor care provoacă stafilococ auriu sunt adesea descrise ca tulpini de Staphylococcus aureus rezistente la Meticilină (MRSA), a dus la utilizarea antibioticelor cu administrarea intravenoasă, cu potențial de a avea mai multe efecte secundare.
Prevenirea infectării cu stafilococ auriu
Poți reduce riscul de infectare cu stafilococ auriu dacă ai grijă:
• Să te speli pe mâini cât mai des;
• Să-ți acoperi rănile deschise de la nivel cutanat până când se vindecă;
• Să-ți schimbi bandajele des, dacă ai leziuni bandajate;
• Să nu folosești la comun cu ceilalți, obiectele de igienă intimă;
• Să-ți speli hainele și lenjeriile la temperaturi ridicate. Pentru a le usca, apelează la un uscător de rufe.
Nu uitați că un diagnostic corect poate fi pus doar de către un medic specialist, în urma unui consult și a investigațiilor adecvate.